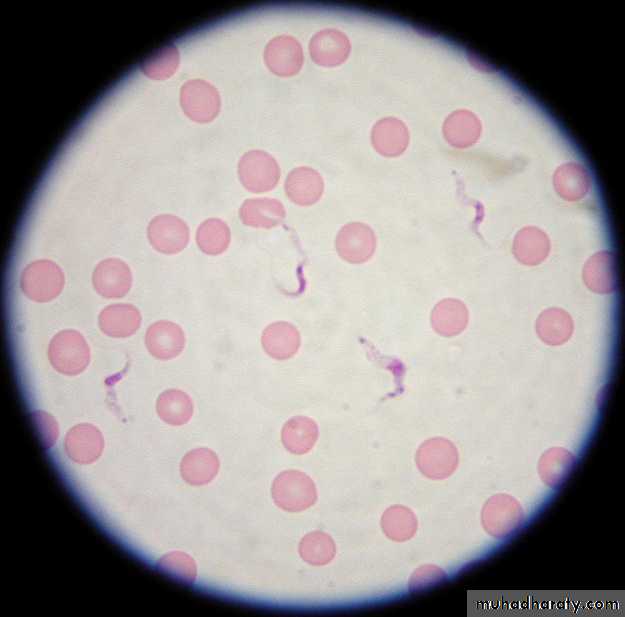
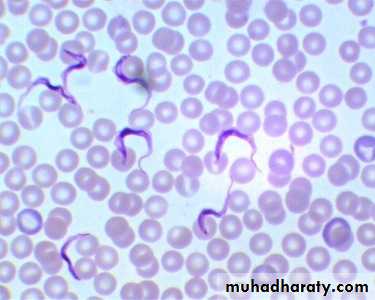

• Lec.5
• Flagellata• Haemoflagellates
Trypanosoma brucei
African trypanosomiasis – sleeping sicknessT. brucei gambiense (Gambian sleeping sickness)
T. brucei rhodesiense (Rhodesian sleeping sicknessTrypanosoma cruzi,
American typansosmiasis (Chagas' disease)
T. b. gambiense
West African sleeping sicknessT. b. rhodesiense
East African sleeping sickness.
Trypanosoma bruci:Haemoflagellates
Trypanosoma cruziDr. Amal KH. KH.
PhD. Medical Parasitology